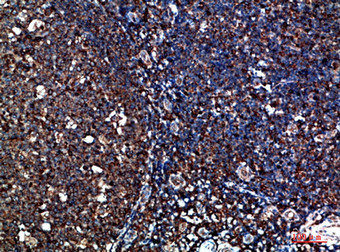

CYFIP2 Antibody
-
中文名稱:CYFIP2兔多克隆抗體
-
貨號:CSB-PA951951
-
規格:¥1090
-
圖片:
-
Western Blot analysis of HEPG2 Hela cells using CYFIP2 Polyclonal Antibody diluted at 1:500. Secondary antibody was diluted at 1:20000
-
Immunohistochemical analysis of paraffin-embedded human-tonsil, antibody was diluted at 1:200
-
Immunohistochemical analysis of paraffin-embedded human-tonsil, antibody was diluted at 1:200
-
Immunohistochemical analysis of paraffin-embedded human-colon, antibody was diluted at 1:200
-
Immunohistochemical analysis of paraffin-embedded human-colon, antibody was diluted at 1:200
-
-
其他:
產品詳情
-
Uniprot No.:
-
基因名:
-
別名:CYFIP2 antibody; KIAA1168 antibody; PIR121Cytoplasmic FMR1-interacting protein 2 antibody; p53-inducible protein 121 antibody
-
宿主:Rabbit
-
反應種屬:Human,Mouse,Rat
-
免疫原:Synthesized peptide derived from CYFIP2 at AA range: 1171-1220
-
免疫原種屬:Homo sapiens (Human)
-
標記方式:Non-conjugated
-
純化方式:The antibody was affinity-purified from rabbit antiserum by affinity-chromatography using epitope-specific immunogen.
-
濃度:It differs from different batches. Please contact us to confirm it.
-
保存緩沖液:Liquid in PBS containing 50% glycerol, 0.5% BSA and 0.02% sodium azide.
-
產品提供形式:Liquid
-
應用范圍:WB,ELISA
-
推薦稀釋比:
Application Recommended Dilution WB 1:500-2000 ELISA 1:10000-20000 -
Protocols:
-
儲存條件:Upon receipt, store at -20°C or -80°C. Avoid repeated freeze.
-
貨期:Basically, we can dispatch the products out in 1-3 working days after receiving your orders. Delivery time maybe differs from different purchasing way or location, please kindly consult your local distributors for specific delivery time.
-
用途:For Research Use Only. Not for use in diagnostic or therapeutic procedures.
相關產品
靶點詳情
-
功能:Involved in T-cell adhesion and p53/TP53-dependent induction of apoptosis. Does not bind RNA. As component of the WAVE1 complex, required for BDNF-NTRK2 endocytic trafficking and signaling from early endosomes.
-
基因功能參考文獻:
- Study characterized the functional roles of the two brain-specific phosphorylation sites (S582 and T1067) of CYFIP2 in cultured hippocampal neurons; found that overexpression of the phospho-blocking T1067A mutant significantly decreased the density of stubby spines, but not other types of spines. Study found that T1067 phosphorylation of CYFIP2 could potentially weaken the interaction between CYFIP2 and Nap1. PMID: 28692454
- Increased expression of the cytoplasmic FMR1-interacting protein 2 (CYFIP2), a known FMRP interactor, is detected in fragile X syndrome. PMID: 22268788
- The CYFIP2 promoter contains a p53-responsive element that confers p53 binding as well as transcriptional activation of a heterologous reporter. PMID: 17245118
-
亞細胞定位:Cytoplasm. Nucleus. Cytoplasm, perinuclear region. Cell junction, synapse, synaptosome.
-
蛋白家族:CYFIP family
-
組織特異性:Expressed in T-cells. Increased expression is observed in CD4(+) T-lymphocytes from patients with multiple sclerosis (at protein level).
-
數據庫鏈接:
Most popular with customers
-
YWHAB Recombinant Monoclonal Antibody
Applications: ELISA, WB, IHC, IF, FC
Species Reactivity: Human, Mouse, Rat
-
Phospho-YAP1 (S127) Recombinant Monoclonal Antibody
Applications: ELISA, WB, IHC
Species Reactivity: Human
-
-
-
-
-
-